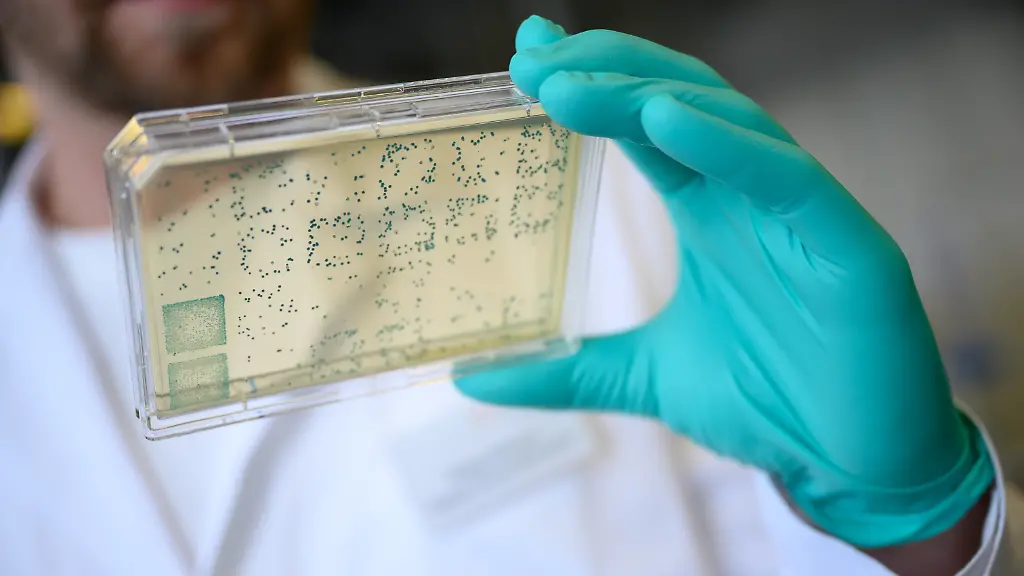
131041848

Suche nach Corona-MedikamentEuropa nimmt klinische Tests auf
Weltweit forschen Institute und Firmen an einem Mittel gegen die Lungenkrankheit Covid-19. In mehreren EU-Ländern werden derzeit experimentelle Methoden an 3200 Versuchspersonen getestet. Der Versuch erfolge "unter strikter Aufsicht", versichert Frankreichs Gesundheitsministerium.
In Europa beginnen klinische Tests von vier experimentellen Methoden zur Behandlung von Covid-19. Bei den Tests an rund 3200 Versuchspersonen kämen die Mittel Remdesivir, Lopinavir sowie Ritonavir mit oder ohne die Wirkstoffe Interferon Beta und Hydroxychloroquin zum Einsatz, teilte die französische staatliche Forschungseinrichtung Inserm mit.
Getestet werden soll demnach an Patienten in Frankreich, Deutschland, Belgien, Luxemburg, den Niederlanden, Spanien und Großbritannien, die mit dem Coronavirus infiziert sind und deswegen in einem Krankenhaus behandelt werden.
Der Generaldirektor im französischen Gesundheitsministerium, Jérôme Salomon, erläuterte, die Medikamente würden "unter strikter Aufsicht" getestet. Es sei "sehr wichtig, es schnell und unter diesen Bedingungen zu tun", fügte er mit Blick auf die weltweit massiven Folgen der Coronavirus-Pandemie hinzu. Die Testreihe trägt nach Salomons Angaben den Namen "Discovery" (Entdeckung), außerdem laufen laut Inserm weitere klinische Tests unter Führung der Weltgesundheitsorganisation (WHO) unter dem Namen "Solidarity" (Solidarität).
Bislang sind keine Medikamente für die Behandlung des Coronavirus zugelassen. In aller Welt forschen Institute und Firmen an Mitteln gegen den Erreger der Lungenkrankheit Covid-19.
Weltweit haben sich nach offiziellen Angaben mehr als 324.000 Menschen mit dem Coronavirus infiziert, rund 14.400 Infizierte starben. Wegen der Pandemie beschlossen zahlreiche Länder drastische Schutzmaßnahmen wie Grenzschließungen und Ausgangsbeschränkungen, die die Weltwirtschaft massiv beeinträchtigen.